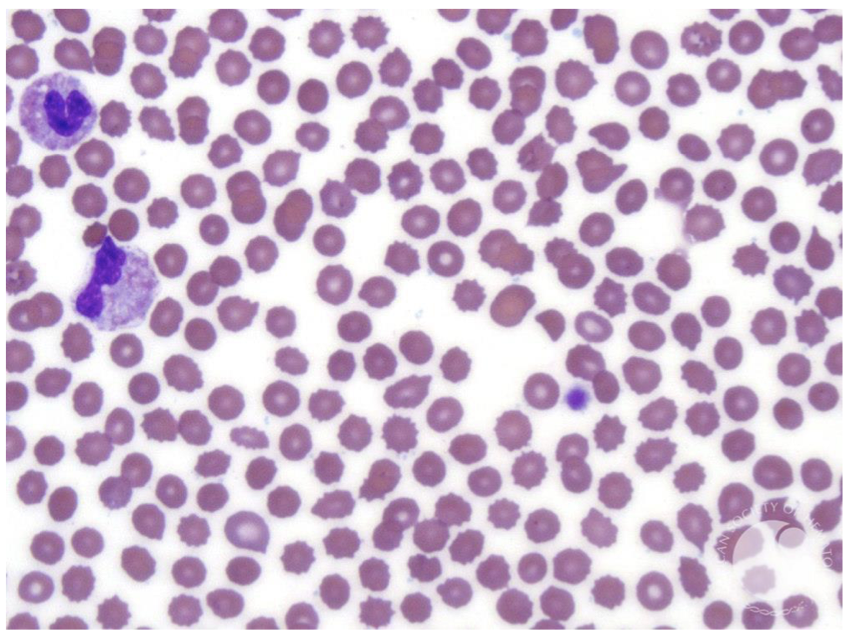
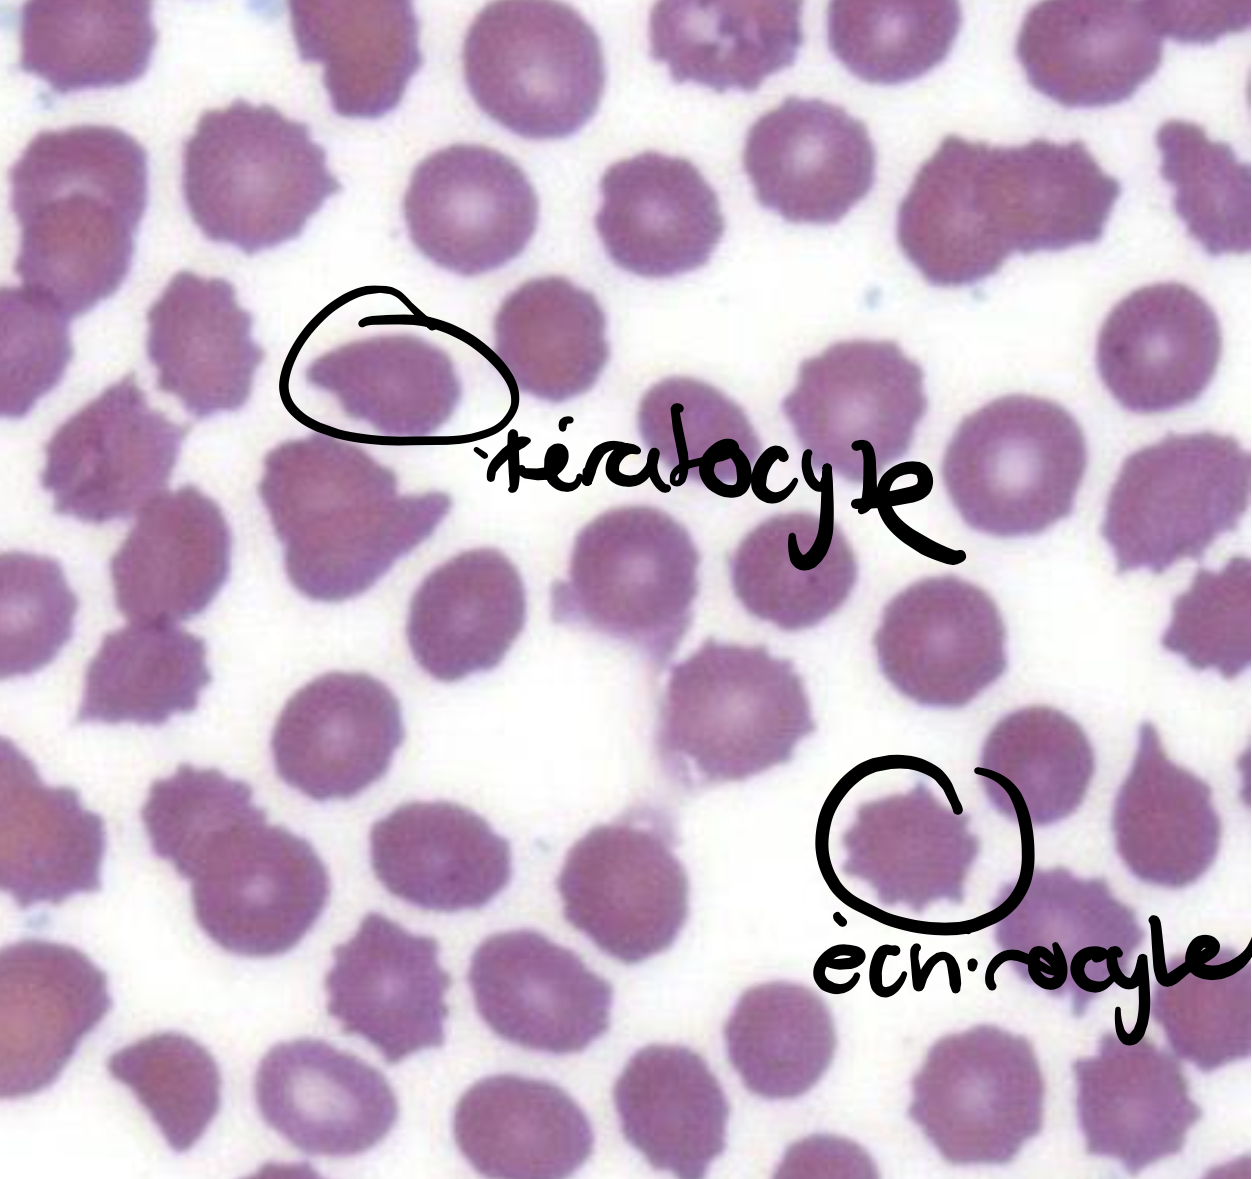

Cas 4

Frottis du Cas 4
Décrit ce qui est observé au frottis du Cas 4
- Poikilocytose
(plusieurs formes GR) - Echinocytes et kératocytes
(suggère mx métaboliques du foie/rein) - Vitesse de sédimentation auguementée (comme CRP ça suggère un état inflammatoire)
Keratocyte: cell w/ protruding end
Echinocyte: cell w/ spikes
Kératocyte: cell w/ protuding end
Quels sont les 5 éléments à analyser PRIMORDIALEMENT dans une FSC
- Leucocytes
- Hémoglobine
- CGM
- Plaquettes
- Réticulocytes
Selon la FSC, combien de GB dans le sang?

(10.5 x 10^9)/L
Selon la FSC, combien de neutrophiles dans le sang?

(8.4 x 10^9)/L
0.8 x (10.5 x 10^9) = 8.4 x 10^9
Valeur normale: 2.0-7.5
Légère neutrophilie
Selon la FSC du Cas 4, quel serait le type d’anémie le plus probable

Normochrome normocytaire
Hémoglobine : 60g/L (N 118-160)
VGM: 90fl (N 82-94)
*VGM normale indique une taille moyenne normale des globules
Selon la FSC du Cas 4, lequel des 5 éléments est anormal?
Réticulocytes

Quel est le terme qui définie des valeurs de réticulocytes abaissées
Réticulopénie
Comment appele-t-on une anémie avec réticulopénie
Anémie non-regénérative
Dans le Cas 4 la dame souffre d’une anémie normocytaire normochrome non-regénérative
Quelle est la cause général des anémies non-regénératives?
Atteintes à la production des érythrocytes
Les réticulocytes sont des formes immatures d’érythrocytes. Quand on est en anémie, le corps devrait typiquement auguementer la productions d’érythrocytes, auguementant alors le nombres de réticulocytes. Une réticulopénie pointe vers un problème de synthèse central (dans la moelle) et NON de déstruction des GR en périphérie (dans le sang)
Selon la FSC du Cas 4, quel serait le diagnostic différentiel
Rappel:
1. Anémie normocytaire normochrome
2. Réticulopénie (non-regénérative)
3. Légère neutrophilie
La réticulopénie pointe vers un problème de production central (dans la moelle) et NON de déstruction des GR en périphérie (dans le sang)
Options possibles:
- Atteinte moelle osseuse
MAIS leucocytes et plaquettes sont N
si il y avait atteinte de moelle elle-même, il y aurait pancytopénie - Manque de facteur de croissance pour erythropoïèse
- Patiente avec INS. RENAL AVANCÉE - Absence de réponse à l’EPO
- Anémie des maladies chroniques

Quels serait les investigations complémentaires à faire pour le Cas 4
- Créatinine
pour insuffisance rénal - Dosage EPO
- Rx pulmonaire
jsp pourquoi c’est silly goofy - Bilan inflammatoire (martial)
pour rule out une anémie par inflammation chronique ig
EPO est produite par quel organ?
Rein
Appareil juxtaglomérulaire
Décrire la production d’EPO
Production stable
Qu’est-ce qui influence la production d’EPO
- Insuffisance rénale
- Paramètres inflammatoires
Réponse thérapeutique
Préalable: pas d;autres cause d’anémie dont ferriprive
Autres mécanismes physiopathologiques pr le cas 4
La prof est passé vrm quick la dessus
genre ongod 30s

Cas 5

Selon la FSC du Cas 5 lesquels des 5 éléments à analyser sont anormaux?

Hémoglobine : 68g/L anémie
VGM: 95fl legèrement macrocytaire
Reticulocytes: 180x10^9 réticulocytose
Anémie regénérative
la réticulocytose montre un effort de regénérer es érythrocytes donc production médullaire est adéquate
Expliquez les observations au frottis du Cas 5
- Polychromatophilie
- Présence de sphérocytes
- Polychromatophilie
c’est simplement parce que le cytoplasme des réticulocytes est teinté bleu. Puisqu’on est en réticulocytose, le frottis est plus bleuté - Sphérocytes (le GR est en forme de sphère plutôt que biconcave)
Ceci arrive quand la membrane de l’érythrocyte a des parties “enlevée”.
Il existe deux causes générales:
- Intrintsèque (génétique): la membrance est mal attachée au cytosquelette
- Extrinsèque (immune ou non): anticorps, allo-immun mère-bébé, médicaments, brûlures, troubles electrolytiques importants

Quel serait le type d’anémie le plus probable du Cas 5
Rappel:
Anémie regénérative d’allure normochrome/normocytaire
Présence de sphérocytes
Anémie Hémolytique
- Les GR sont en forme de sphère, signe qu’elles se font attaquer
- Le patient a un ictère, signe d’hémolyse
- La production médullaire semble adéquate. Nous pouvons alors penser à de la destructionn des GR dans le sang périphérique
- Le patient a été exposé à de la péniciline. Il y a peut-être eu une réaction croisé avec le Gr
Quel est le diagnostic différentiel des anémies hémolytiques?
aka. c’est quoi les autres causes d’anémie hémolytique
- Traumatisme intravasculaire (ex. valves métalliques, malformation artério-veineuses
- Microangiopathies
Associé à des schizocytes (GR en fragments) plutôt que sphérocytes
Schéma résumé des cause de l’anémie NORMOCYTAIRE













